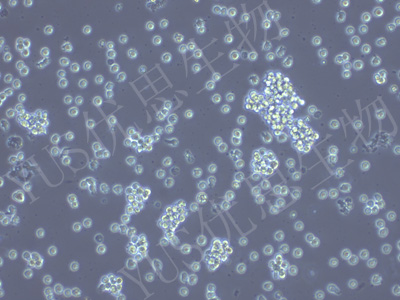

产品中心
产品中心
-

U-2932 人弥漫大B淋巴瘤细胞(STR鉴定)
货号:YLH495规格: 1*10^6 -

VK2/E6E7 人阴道上皮细胞(STR鉴定)
货号:YLH496规格: 1*10^6 -

EOL-1 人急性髓细胞白血病细胞(STR鉴定)
货号:YLH497规格: 1*10^6 -
SUP-T1 人T淋巴母细胞瘤细胞(STR鉴定)
货号:YLH498规格: 1*10^6 -

TMD8 人弥漫性大B淋巴瘤细胞(STR鉴定)
货号:YLH499规格: 1*10^6 -

SK-MEL-5 人皮肤黑色素瘤细胞(STR鉴定)
货号:YLH500规格: 1*10^6 -

NCI-H660 人神经内分泌前列腺癌细胞(STR鉴定)
货号:YLH501规格: 1*10^6 -

IGROV-1 人卵巢癌细胞(STR鉴定)
货号:YLH502规格: 1*10^6 -

KPL-4 人乳腺癌细胞(STR鉴定)
货号:YLH503规格: 1*10^6 -

293T/17 人胚肾细胞(STR鉴定)
货号:YLH504规格: 1*10^6 -

NCI-H2030 人非小细胞肺癌细胞(STR鉴定)
货号:YLH506规格: 1*10^6 -

A-427 人肺癌细胞(STR鉴定)
货号:YLH507规格: 1*10^6
在线咨询
Online consultation

关注微信公众号


